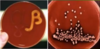

What is the most common bacteria in the healthy periodontium?
Low numbers of gram positive bacteria predominate in healthy gingival and periodontal tissue. E.g. Streptococcus bacterial family whichoccur in 100% of isolation speciments.
What is co-aggregation?
It is a process by which bacteria bind together. Some bacteria may have adhesins on their cell wall that are able to bind to the receptors on the cell wall of other bacteria.
What are the pioneers of the dental plaque?
Streptococcus family
What happens to the number of bacteria in gingivitis?
The number of bacteria and diversity of bacteria increases in plaque induced gingivitis. This is associated with hightened immune response.
GCF has nutrients that increase the number of bacteria.
What bacterial shift is associated with periodontitis?
The bacterial shift that associated with periodontitis is a shift from facultative gram positive bacteria to anaerobic gram negative bacteria. It is important to state that this shift is seen in cultivable gingival micro-flora meaning this statistic is only understood in lab grown bacteria.
The level of cultivated bacteria also explain why gingivitis is considered a transitional stages, because in gingivits it can be seen that the bacterial makeup is relatively equal.
Why finding the aetiology of periodontal disease and contribution of bacteria so hard to establsh?
- Lack of understanding of progression
- Difficulaties in sampling
- Many of the pathogens are also belived to be par of normal microbiota
- Complex interactions of pathogen and host are involved
What are the common bacteria that are associated with chronic periodontists?
- P. Gingivalis
- T. denticola
- T. Farsythia
- A. Actinomycetemcomitans
And more but 75% of them are gram negative and nearly all are strict anaerobes
What can you say about the metabolism of bacteria associated with chronic periodontitis?
They are predominantly asaccharolytic and anerobic thus meaning they use amino-acids for metabolism thus propagate during the breakdown of proteins.
Why is the orange group bacteria so essential for the dominance of the red group bacteria?
Because orange group bacteria consume oxygen thus are able to reduce the amount of available oxygen thus increasing the number of anaerobic organisms.
Why does the pH of the sulcus increases with the introduction of more anerobic species?
This occurs due to decrease in oxygen and redox potential thus increasing the number of available hydrogen ions thus decreasing the pH of the environment.
What are the virulence factors that are asosciated with aeitology of perdiodontitis?
- Attachemnt - cell surface through adhesins
- Multiplication - enzymes to obtain nutrients through tissue damage of the host tissue
- Evasion of defense - capsule production, leukotoxin production and other
- Tissue damage - direct - through collagenese, hyaluronidase, bone resorbing factors, cytotoxins and more
- Tissue damage - indirect - through hightening of the inflammatory response
Where would you find adhesins?
- Root surface
- Gingival epithelial cells
- Co-aggregation with other microbes
What are multiplication mechanism used by periodontal bacteria?
- Range of proteases for break down of protein matrix for nutrients
- Glycosidases - break down of glycoproteins for carbohydrates
These enzyme activities are considered to be complimentary because many bacteria collaborate to provide their own enzymes to benefit different bacteria that may benefit from tissue breakdown.
What are some of the evasion mechanisms used by periodontal bacteria?
- Production of serotype B - cause lyse of neutrophols, monocytes and lymphocytes
- Production of molecules that interfere with polymorph function like chemotaxis and phagocytosis
- Proteases degrade components of immune system
- Capsule production for immune system evsion
What are the mechanism of direct tissue damage used by periodontal bacteria?
Use of multiple proteases that are able to degrade fibrinogen, collagen, transferrin, IgG, IgA as well as host protease inhibitors.
What are some of the treatments of periodontal disease?
- Plaque control
- Professional debridement
- Potentially antibiotic therapy
What is apical periodotitis & endodontitis?
It is an inflammatory process in the peri-radicular tissues, primarily caused by a polymicrobial infection within the root canal system.
It could be symptomatic or asymptomatic.
What is endodontic therapy?
It a process of elimination of the causative agents, thereby providing an environment (sterile) conducive to healing.
Basically - remove as much bacteria from he root canal system as possible.
What bacteria is associated with endodontic bacteria?
Mainly anaerobic bacteria - becauses of low oxygen availability within the pulpal tissue (autogenic succession - driven by bacterial consumption of oxygen) - anaerobic bacteria are very destructive due to their fastidious nutritional requirements
What are some of the routes of entry of bacteria into the pulp?
- Caries
- Mechanical exposure
- Trauma
- Anachoresis - bacteremia
- Periodontal pockets - when pockets reach root apex

What factors influence bacterial composition in the pulpal infection?
- Redox potential decreases over time
- Nutrient supply and composition
- Host immuno-competence
- Bacterial inter-relationship - polymicrobial infections require many bacteria
What is antagonistic microbial interaction?
It is a net negative interaction - competition for nutrients, production of toxic metabolites and other
What is synergistic microbial interaction?
It is a net positive interaction - consumption of O2, production of nutrients for other bacteria
What are some of the locations found in tooth non hard tissue?
- Root canals
- Lateral/ accessory canals
- Dentine tubules
- Extra-radicular tissues